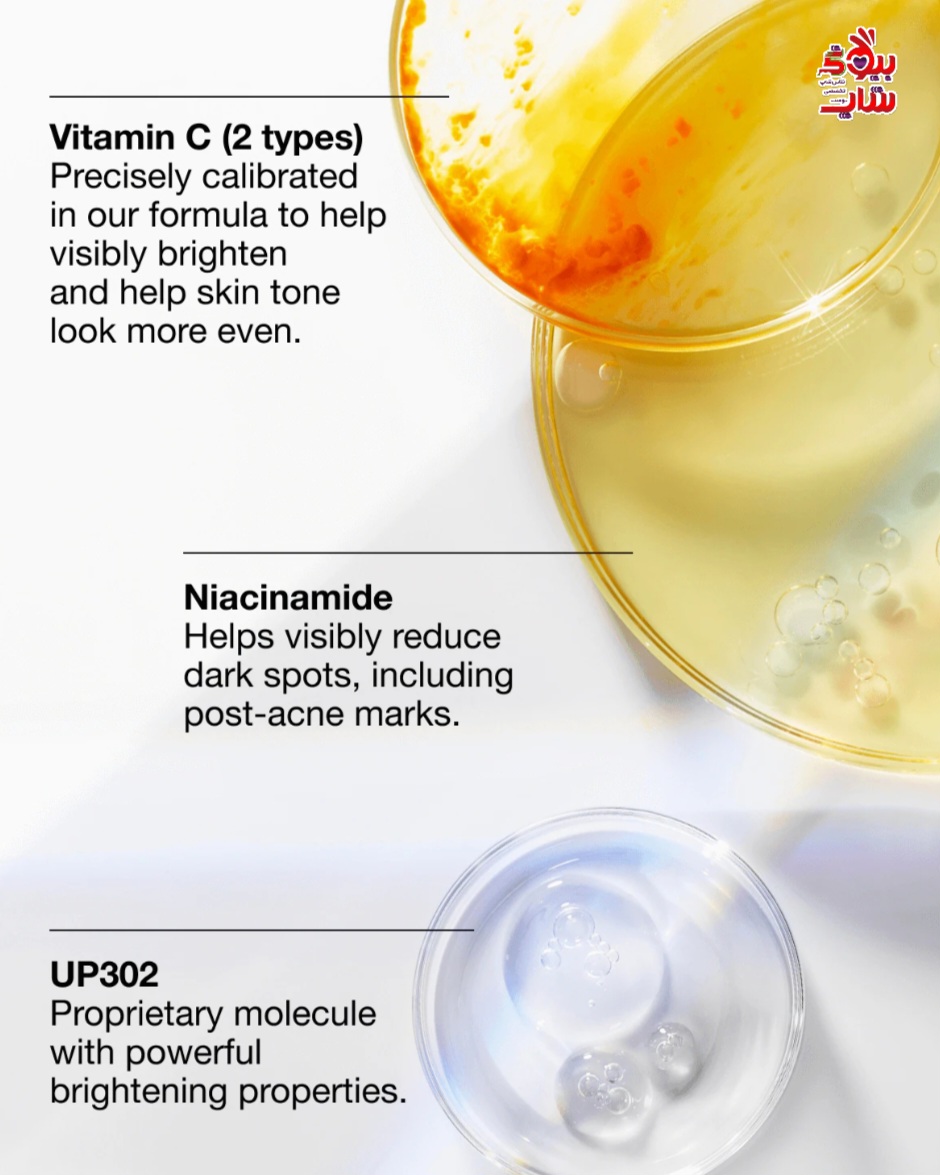

آیا از لکههای تیره روی پوستتان خسته شدهاید؟ سرم درمان لک کلینیک 30 میل، راهحل شماست! این سرم اورجینال با فرمولاسیون پیشرفته به سرعت لکههای تیره را کاهش میدهد و پوستی یکنواخت و درخشان به ارمغان میآورد. به اعتماد به نفس بیشتری دست یابید و زیبایی طبیعی خود را درخشان کنید!سرم روشنکننده لکههای تیره نسل چهارم ما، یک راهحل قدرتمند توسعهیافته توسط متخصص پوست برای هایپرپیگمنتاسیون است. فرمول پیشرفته، شامل مولکول اختصاصی UP302 ما، ترکیبات روشنکننده قویتر را با ترکیبات تسکیندهندهتر متعادل میکند.
محصولات مرتبط
سرم مرطوب کننده گلو رسپی هندوانهای درخشان صورتی Glow Recipe Watermelon Glow Pink Juice Moisturizer 25ml
دابل سرم ضد چروک و جوانساز کلارنس 75میل اورجینال CLARINSE DOUBLE SERUM - Anti- Aging + Anti- Wrinkle Serum
دابل سرم ضد چروک و جوانساز کلارنس 50میل اورجینال CLARINSE DOUBLE SERUM - Anti- Aging + Anti- Wrinkle Serum
سرم لایه بردار مندلیک و لاکتیک اسید پائولا چویس اورجینال PAULA'S CHOICE SKINCARE 6% Mandelic Acid + 2% Lactic Acid Liquid Exfoliant
ضد آفتاب فلوئیدی کنترل و درمان لک اوسرین اورجینالEUCERIN SUN PROTECTION Eucerin Sun Face Pigment Control SPF50+ 50ml
روغن جوانساز رز و ویتامین سی اسکوالان بایوسانس اورجینال BIOSSANCE Squalane and Vitamin C Rose Oil 30ml
شوینده ویتامین سی و روشن کننده مورد 200میل اورجینال MURAD Brighter skin starts with Essential-C Cleanser
What it is
Our fourth generation brightening dark spot serum is a powerful dermatologist-developec solution for hyperpigmentation. The advanced formula, including our proprietary molecule UP302. balances more potent brightening actives with more soothing ones.
*Gentle enough for all skin types, including sensitive skin
Dermatoloaist developed and tested. Safe for sensitive skin. Tested on all skin tones. Allergy tested. 100% fragrance free.
Please note: This product is excluded from discounts.
Product Details
Targets tough dark spots Visibly reduces stubborn dark spots, including sun spots, age spots, and post-acne marks.
Helps prevent future dark spots Helps visibly soothe skin from environmental iritants that can trigger future hyperpigmentation.
Delivers results you can see
Skin looks brighter and more radiant, with a more even-looking tone.
Feel-good texture
Lightweight, oil-free formula sinks in quickly.
How To Use
• Use our serum for dark spots twice a day, morning and night • Dispense 1 to 2 pumps onto fingertips ‣ Spread dark spot serum all over your face, avoiding eye area, • Follow with moisturizer
‣ Daily sunscreen is imperative. Apply in the AM after your moisturizer
More responsible packaging
• 30ml, 50ml, and 75ml bottles are packed in recyclable glass bottles
• To recycle the bottle, remove the pump, then rinse the bottle and place in a recycling bin. ‣ Carton is made from responsibly sourced paperboard. Please recycle,
Results
Proven to visibly reduce tough dark spots on different skin tones:
• Up to 49% visible reduction in sun and age spots on lighter skin tones.* ‣ Up to 56% visible reduction in post-acne mark intensity on deeper skin tones.** "Clinical testing of 53 panelists after 12 weeks showed 49% visible improvement in top responders (22 of 53 panelists and a 34% average visible improvement across all 53 panelists.
**Clinical testing of 34 panelists after 12 weeks showed 56% visible improvement in top responders (9 of 34 panelists) and a 37% average visible improvement across all 34 panelists.
Key Ingredients
Our advanced brightening formula is powered by:
UP302
Researchers screened over two thousand plant extracts and found dianella ensifolia to have powerful properties. UP302, Clinique's proprietary brightening molecule, was pioengineered to mimic the botanical and founc to have powerful antioxidant and brightening benefits.
Vitamin
This serum is made with two types of vitamin C -magnesium ascorbyl phosphate and ascorby glucoside--for precisely calibrated formulation. Together these potent brightening antioxidants nelp visibly reduce dark spots, including post- acne marks, and help skin tone look more even,
Pure niacinamide
Helps visibly reduce discoloration such as dark spots and post-acne marks,
Salicylic acid
Gently sloughs off the uppermost layers of the skin to help reveal fresher, more even-looking skin.
Glucosamine
Helps weaken the bonds that hold dead skin cells together to encourage the exfoliation of surface discoloration for brighter, more even- looking skin.
And it's balanced by:
Glycyrrhetinic acid, derived from licorice extract
A potent anti-irritant, it helps calm skin by visibly reducing skin irritation that could trigger dark spots.
Gyokuro
This green tea is hand-harvested in Japan in such a way that its natural anti-irritant properties are optimized for full potential. Helps
quell the look of irritation that could lead to discoloration.
Formula Facts Clinical Expertise
• Dermatologist developed • Dermatologist tested • Safe for sensitive skin • Suitable for post-procedure skin* • Tested on all skin tones . Allergy tested • Fragrance free . Non-acnegenic
*Shown to be safe for use beginning 1 day after Intense Pulsed Light (IPL) treatment in 2 week clinical usage test.
Free of
Fragrance Parabens
Oil
Drying alcohol
Sodium lauryl sulfate
Sodium laureth sulfate
Synthetic colors
.
.

Ingredients
Ingredients: Water\Aqua\Eau, Dimethicone, sododecane. Yeast Extract\Faex\Extrait De Levure, Butylene Glycol, Polysilicone-1 1 \iacinamide, Ascorbyl Glucoside, Peg-10 Dimethicone, Peg-6, Acetyl Glucosamine Glycerin, Sodium Hyaluronate, Squalane Cholesterol, Helianthus Annuus (Sunflower Seed Extract. Trametes Versicolor Extract. Glycyrrhiza Glabra (Licorice) Root Extract lordeum Vulgare Extract\Extrait D'Orge, Oryza Sativa (Rice) Bran Extract, Triticum Vulgare Wheat) Germ Extract, Cucumis Sativus Cucumber) Fruit Extract, Camellia Sinensis Leaf Extract. Caffeine. Salicvlic Acid sohexadecane, Propylene Glycol Dicaprate Glycyrrhetinic Acid, Dimethoxytoly Propylresorcinol, Caprylyl Glycol Stearamidopropyl Dimethylamine. Phosphatidylcholine, Sorbitan Oleate. Polysorbate 20, Polysorbate 80. Stearic Acid, fexylene Glycol, Tromethamine, Citric Acid Acrylamide/Sodium Acryloyldimethyltaurate
Copolymer, Ammonium Acryloyldimethyltaurate/Vp Copolymer
Tocopheryl Acetate, Magnesium Ascorbyl Phosphate, Bht, Sodium Citrate, Disodium Edta, Nylon-12, Phenoxyethanol <ILN52877>
Please be aware that ingredient lists may change or vary from time to time. Please refer to the ingredient list on the product package you receive for the most up tO date list of ingredients.

دیدگاه خود را بنویسید